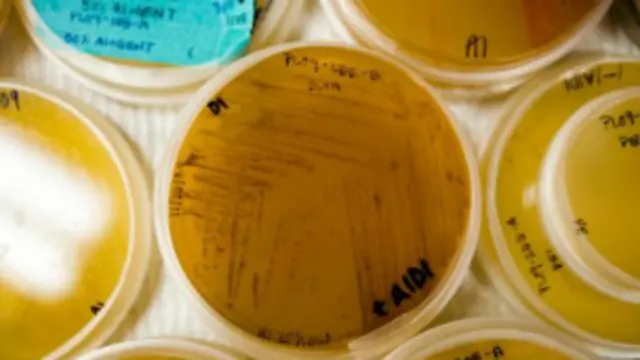
ماہرین کا کہنا ہے کہ عالمی سطح پر نئی نسل کے بیکٹیریا کی دوا پر تحقیق کرنے کی ضرورت ہے

بیکٹیریا کی نئی نسل جدید طب کے لیے سب سے خطرناک
طبی ماہرین کے ایک عالمی کمیشن نے آگاہ کیا ہے کہ جدید طب یا میڈیسن کو سب سے زیادہ ایسے بیکٹیریا یا جراثیم سے خطرہ لاحق ہے جو دواؤں کے خلاف مدافعت پیدا کرتے جا رہے ہیں۔
یہ تحقیق طبی جریدے ’دا لانسٹ‘ میں شائع ہوئی ہے۔
جریدے میں شائع رپورٹ میں ماہرین نے نئي نسل کے بیکٹیریا کے خطرے سے نمٹنے کے لیے پہلے سے کہیں زیادہ عالمی تعاون پر زور دیا ہے۔
ماہرین کا کہنا ہے کہ ’ہم اینٹی بایوٹک یا بیکٹیریا کو ختم کرنے والے دور کے بعد والے دور میں قدم رکھ چکے ہیں۔‘
ان کا کہنا ہے کہ مستقبل قریب کے چند برسوں میں اگر بیکٹیریا کے خطرناک اثرات سے بچنا ہے تو فوری طور پر عالمی سطح پر سرگرم ہونے کی ضرورت ہے۔
اس کے تحت موجودہ اینٹی بایوٹک ادویہ کے استعمال میں کمی اور دوا بنانے والی کمپنیوں کو بیکٹیریا مخالف دوسری قسم کی نئی دوائیں بنانے کے لیے مراعات کی ضرورت پر زور دیا گیا ہے۔
برطانوی ڈاکٹر پیٹر سوئن یارڈ نے اس حوالے سے برطانوی اخبار ’دی انڈیپنڈنٹ‘ سے بات کرتے ہوئے کہا کہ ’مریض کی توقعات میں تبدیلی کی ضرورت ہے۔ ہمیں لوگوں کو یہ بتانے کی ضرورت ہے کہ ہر قسم کی بیماری کے لیے ضروری نہیں کہ گولی کھائی جائے۔‘
انھوں نے یہ بھی کہا کہ ’ما بعد اینٹی بایوٹک زمانے میں ہو سکتا ہے کہ سرسام یا نمونیا جیسی بیماری کا علاج اینٹی بایوٹک سے نہ ہو سکے اور مریض دم توڑ دے جبکہ آج اس کا علاج ہو جاتا ہے۔‘
End of سب سے زیادہ پڑھی جانے والی

انھوں نے کہا کہ ہر چھوٹی موٹے مرض کے لیے اینٹی بایوٹک لینے سے پرہیز کرنا چاہیے نہیں تو مستقبل میں اس کے خطرناک اثرات ہو سکتے ہیں۔
رپورٹ میں کہا گیا ہے کا اس سلسلے میں یہ تحقیق کرنے کی اشد ضرورت ہے کہ کس طرح اینٹی بایوٹک دواؤں کے خلاف مدافعت کی صلاحیت والی نسل کے بیکٹیریا تیار ہو رہے ہیں۔
ماہرین نے متبنہ کیا ہے کہ ’بغیر مؤثر اینٹی بایوٹک ادویہ کے چھوٹی موٹی سرجری سے لے کر کینسر جیسے مرض کی کیمو تھراپی جیسے علاج ناممکن ہو جائیں گے اور ترقی یافتہ ممالک میں اموات کی شرح وہیں پہنچ جائے گی جہاں وہ بیسویں صدی کے شروع میں تھی۔‘
انھوں نے یہ بھی کہا ہے کہ ’علاج پر آنے والے اخراجات میں زبردست اضافہ ہو جائے گا کیونکہ ہمیں نئی اور زیادہ مہنگی دواؤں کا استعمال کرنا پڑے گا اور بیماری سے صحت یابی کے لیے ہمیں زیادہ مدت تک ہسپتال میں رہنا پڑے گا۔‘
سویڈن کی اپسالا یونیورسٹی کے پروفیسر اوٹوکار نے لانسٹ میں لکھا ہے کہ ’اینٹی بایوٹک دواؤں کے خلاف مدافعت پیچیدہ ماحولیاتی مسئلہ ہے جو نہ صرف انسانوں کو متاثر کرتا ہے بلکہ یہ زراعت اور ماحولیات سے بھی بہت زیادہ جڑا ہوا ہے۔
’ہمیں اس مسئلے کے تحت الزام تراشی اور شرمسار کرنے سے باز رہنے کی ضرورت ہے اور ایک ٹھوس سیاسی قدم اٹھانے کی ضرورت ہے جو اس خطرے سے نمٹ سکے۔‘







